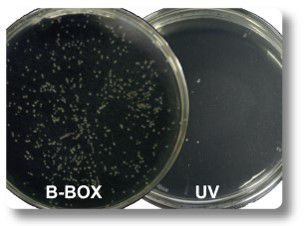
Odoo - Sample 3 for three columns

B-BOX™藍光 LED照膠儀
Description
SMOBIO’s B-BOX™ is a long wavelength, blue light LED epi-illuminator. It is compact in design and robust in structure. The B-BOX™ epi-illuminator provides an unprecedented level of safety for its user due to its non-UV light source and a low operating voltage of only 12 Volts, as well as its capability working with non-carcinogenic DNA/ protein dye. The B-BOX™ comes with high quality non-flickering LED light that is highly sensitive for DNA and protein dye. B-BOX™ can greatly ease the routine chore of gel extraction, enabling easy visualization and gel cutting even in bright ambient light. The multi-angle filter plate (Cat. No. VE0102) provides optimal angles for gel cutting, visualization, and documentation. The B-BOX™ also comes with amber colored filter goggles (Cat. No. VE0103) for gel cutting and visualization. The Phox™ Photobox (Cat. No. VE0104) provides a mini darkroom environment for images taken with any smartphone. Finally, a built-in barrier system around the working area helps facilitate cleaning.
Features
Improved cloning efficiency
Compact, lightweight, and portable (less than 1 kg in weight)
Safety features include : 470 nm long wavelength, without any UV radiation hazard to its user
Compatible with non-carcinogenic, non-ethidium bromide DNA staining dye
User friendly: Samples are easy to visualize (when using the filter plate or goggles)
LED light source lasts up to 50,000 hours
Superior detection sensitivity: ≤ 0.04 ng of DNA when using FluoroStain™ DNA Fluorescent Staining Dye, ≤3 ng of protein when using FluoroStain™ Protein Fluorescent Staining Dye (as sensitive as silver stain)
Adjustable and removable filter plate allows for gel cutting, visualization, and documentation
Built-in barrier design, for easy clean up
Visible in bright ambient light
Emphasizes minimal power reliance, low heat generation, with its own built-in heat sink
Accessories
|
B-BOX™ Blue Light LED Epi-illuminator, DC 12 Volt, 0.72 Amp |
x1 |
|
Adapter, AC 100-240V, 50/60 Hz, 1.8 m Power Cord |
x1 |
|
Multi-angle Filter Plate for B-BOX™ |
x1 |
|
Amber Goggles for B-BOX™ |
x1 |
|
Phox™ Photobox |
x1 |
|
Instruction Manual |
x1 |
|
Warranty Card |
x1 |

Wavelength of Blue light LED (nm)
Advantages of using B-BOX™ Blue Light LED Epi-illuminator
SMOBIO's Phox™ Photobox assembly

Multiple angle filter plate

Easily accessible operating area

DNA/Protein bi-functional
100X increased cloning efficiency
Physical Specifications
Accessories
|
Why do we use blue light and safe dye to view and/or cut gel?
Traditional methods involve the use of EtBr/UV light to view gel. These traditional methods have been replaced with safer dyes and imagers like SMOBIO’s B-BOX™ blue light epi-illuminator. Using SMOBIO’s B-BOX™ / SMOBIO fluorescent dye (DS1000, NS1000, DL5000) you can improve your cloning efficiency up to 100 times. It is user friendly and easy to operate. Furthermore, blue light is safer for users in comparison to the use of UV light.
What is the service life for B-BOX™ and the lamp life of the LED bulb?
B-BOX™ can last up to five years under regular use. The lamp life of the LED bulb is approximately 50,000 hours.
Can EtBr-stained agar gel be visualized in B-BOX™?
Yes, you can view EtBr stained gel with B-BOX™ and results will appear red in color. However, you will experience reduced sensitivity because EtBr’s optimal wavelength of excitation lies in the range of UV light.
How can we match B-BOX™ to a conventional UV gel imaging system?
For the purpose of taking pictures, the whole device of B-BOX™ epi-illuminator can be directly placed inside a conventional UV gel imaging system. If the B-BOX™ acrylic sheet filter is placed, the filter of the imaging system can be removed. However, we suggest to use general digital camera or smart phone for convenient and efficient imaging.
Can B-BOX™ be used without a power supply cord?
Yes, B-BOX™ can be used without the use of a power supply cord when you purchase a specialized battery box that uses AA batteries.
When using the cordless battery box of B-BOX™, which battery type is recommended for use?
We recommend using 8 pieces of 1.2 V NiMH rechargeable batteries. It is also possible to use alkaline batteries which can last up to 24 hours under continuous operation. Using B-BOX™ for 8 minutes per day will give you the equivalent of 6 months of battery use.
Rossella Colabelli Gisoldi, Gemma Lodato, Bijorn Omar Balzamino, Graziana Esposito, Alessandra Micera, Augusto Pocobelli
Graefes Arch Clin Exp Ophthalmol. 2022 Nov 29 : 1–9. doi: 10.1007/s00417-022-05909-x
PMCID: PMC9707145
Bijorn Omar Balzamino, Graziana Esposito, Ramona Marino, Pietro Calissano, Valentina Latina, Giuseppina Amadoro, Flavio Keller, Andrea Cacciamani, and Alessandra Micera
Front Aging Neurosci. 2022; 14: 1015359. Published online 2022 Nov 16. doi: 10.3389 / fnagi.2022.1015359
PMCID: PMC9708893
Acceleration of Yeast Autolysis by Addition of Fatty Acids, Ethanol and Alkaline Protease
Zeinab Takalloo, Robabeh Nemati, Marjan Kazemi, Hadi Ghafari, Reza HasanSajedi, Iran. J. Biotechnol. July 2022;20(3): e3036
Gabriella Chong, Fu-Wen Kuo, Sujune Tsai, Chiahsin Lin Sci Rep. 2017; 7: 39396. Published online 2017 Jan 9. doi: 10.1038/srep39396
PMCID: PMC5220285
Wan-Chen Lee, Kuang-Sheng Yeh BMC Vet Res. 2016; 13: 66. Published online 2017 Mar 1. doi: 10.1186/s12917-017-0986-7
PMCID: PMC5333440

FluoroVue™ Nucleic Acid Gel Stain
Excellent for in-gel staining
Sensitivity up to 0.14 ng DNA or 1 ng total RNA
A safer alternative to EtBr
Suitable to blue or UV light

FluoroStain™ DNA Fluorescent Staining Dye
Excellent for post staining
Sensitivity up to 0.04 ng DNA
A safe alternative to EtBr
Suitable for blue or UV light

FluoroDye™ DNA Fluorescent Loading Dye
Excellent for premix with DNA sample
Sensitivity up to 0.14 ng DNA
Safety dye
Convenience - monitor the electrophoresis in real-time

High Fidelity PCR amplification
Amplification of target gene with HiFi™ DNA polymerase to minimize error rate.

Gel electrophoresis
Staining amplicons with safe fluorescent dyes, following by observation under blue-light illuminator to minimize damage of DNA amplicons and maximize successful cloning efficiency.
Safe fluorescent dyes
[NS1000] FluoroVue™ Nucleic Acid Gel Stain (10,000X), 500 μl
[DS1000] FluoroStain™ DNA Fluorescent Staining Dye (Green, 10,000X), 500 μl
[DL5000] FluoroDye™ DNA Fluorescent Loading Dye (Green, 6X), 1 ml
Blue-light illuminator

Transformation
Prepare competent cells with high efficiency and transform with time-saving protocol.

Colony PCR
Analyze colonies with PCR master mix to save preparation time.




